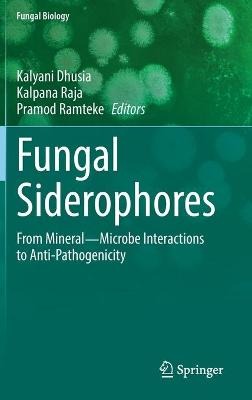
ibs

L’articolo è stato aggiunto alla lista dei desideri
IBS.it, l'altro eCommerce
Fungal Siderophores: From Mineral?Microbe Interactions to Anti-Pathogenicity
Cliccando su “Conferma” dichiari che il contenuto da te inserito è conforme alle Condizioni Generali d’Uso del Sito ed alle Linee Guida sui Contenuti Vietati. Puoi rileggere e modificare e successivamente confermare il tuo contenuto. Tra poche ore lo troverai online (in caso contrario verifica la conformità del contenuto alle policy del Sito).
Grazie per la tua recensione!
Tra poche ore la vedrai online (in caso contrario verifica la conformità del testo alle nostre linee guida). Dopo la pubblicazione per te +4 punti
Altre offerte vendute e spedite dai nostri venditori

Tutti i formati ed edizioni
Promo attive (1)
In the past few decades, it has been realized through research that fungal siderophores epitomize the uptake of iron as well as other essential elements like zinc, magnesium, copper, nickel and arsenic. Understanding the chemical structures of different fungal siderophores and the membrane receptors involved in uptake of mineral ions has opened new areas for research. In this edited volume, recent research is presented on fungal siderophores in one comprehensive volume to provide researchers a strong base for future research. Siderophores are the low molecular weight, high affinity iron-chelating compounds produced by bacteria and fungi. They are responsible for transporting iron across the cell membrane. Fungi produce a range of hydroxamate siderophores involved in the uptake of essential elements in almost all microorganisms and plants. In recent years, siderophores have been used in molecular imaging applications to visualize and understand cellular functions,which thus provide an opportunity to identify new drug targets. Therefore, knowledge of fungal siderophores has become vital in current research. Siderophores have received much attention in recent years because of their potential roles and applications in various research areas. Their significance in these applications is because siderophores have the ability to bind a variety of metals in addition to iron, and they have a wide range of chemical structures and specific properties. For instance, siderophores function as biocontrols, biosensors, and bioremediation and chelation agents, in addition to their important role in weathering soil minerals and enhancing plant growth. This book focuses on siderophores with the following significant points. It discusses leading, state-of-the-art research in all possible areas on fungal siderophores. The contributors are well-known and recognized authorities in the field of fungal siderophores. It discusses aprojection of practical applications of fungal siderophores in various domains. This is the first book exclusively on fungal siderophores. In this comprehensive, edited volume, we show leading research on fungal siderophores and provide the most recent knowledge of researchers' work on siderophores. This book presents in-depth knowledge on siderophores to researchers working in areas of health sciences, microbiology, plant sciences, biotechnology, and bioinformatics.
L'articolo è stato aggiunto al carrello
Le schede prodotto sono aggiornate in conformità al Regolamento UE 988/2023. Laddove ci fossero taluni dati non disponibili per ragioni indipendenti da IBS, vi informiamo che stiamo compiendo ogni ragionevole sforzo per inserirli. Vi invitiamo a controllare periodicamente il sito www.ibs.it per eventuali novità e aggiornamenti.
Per le vendite di prodotti da terze parti, ciascun venditore si assume la piena e diretta responsabilità per la commercializzazione del prodotto e per la sua conformità al Regolamento UE 988/2023, nonché alle normative nazionali ed europee vigenti.
Per informazioni sulla sicurezza dei prodotti, contattare productsafetyibs@feltrinelli.it
L’articolo è stato aggiunto alla lista dei desideri

